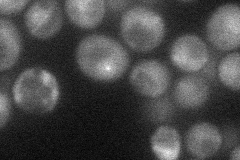
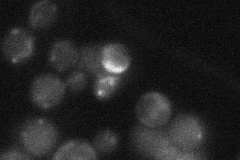

View description
Dual-specificity kinase required for spindle pole body (SPB) duplication and spindle checkpoint function; substrates include SPB proteins Spc42p, Spc110p, and Spc98p, mitotic exit network protein Mob1p, and checkpoint protein Mad1p
Localization:
Intensity:
Fold change:
Significance:
-
C’ GFP library in SD

cytosol19.96 -
N' NOP1pr-GFP in SD
punctate,nucleus30.732 -
N' TEF2pr-mCherry in SD

below threshold13.4499 -
N' NATIVEpr-GFP in SD
punctate21.3209 -
N' TEF2pr-VC and Cyto-VN in SD

#N/A0 -
C’ GFP library in SD+DTT

cytosolN/AN/ANo -
C’ GFP library in SD+H2O2

cytosolN/AN/ANo -
C’ GFP library in Starvation Media

cytosolN/AN/AYes -
C’ GFP library on the background of Pup2-DaMP

cytosol -
C’ GFP library on the background of CCT mutant

cytosolN/AN/ANo
